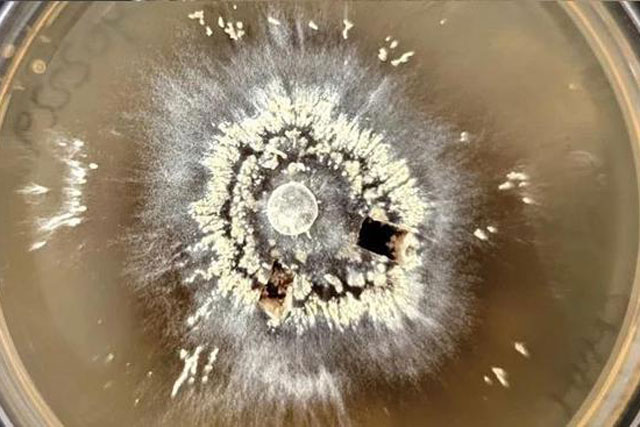
Dàn sinh vật hồi sinh trong "hỏa ngục" ngay trên Trái Đất

Tìm kiếm: ni-tơ
Trong khi các nhà thiên văn vẫn tranh cãi về khả năng sở hữu sự sống mong manhcủa những hành tinh có nhiệt độ khắc nghiệt, thì trong một trận cháy rừng ở California - Mỹ, một đàn sinh vật "hỏa ngục" vừa xuất hiện.
Khát nước, rối loạn tiêu hóa... là biểu hiện cơ thể đang dư thừa chất đạm bạn cần điều chỉnh lại chế độ ăn.
DNVN - Honda Rebel 500 2022 có giá bán 180 triệu đồng. Dưới đây là clip cận cảnh mẫu môtô cruiser này.
DNVN - Honda Rebel 500 2022 vừa được bán chính hãng ở thị trường Việt Nam với giá 180 triệu đồng.
Một sinh vật ẩn nấp dưới đại dương đã "phá vỡ mọi quy tắc sự sống" khi sinh tồn trong môi trường hầu như không có oxy. Chúng vẫn thở, bằng cách tự tạo ra oxy mà không cần ánh sáng.
Các nhà khoa học đã phát hiện ra một nguồn khí cười khổng lồ và đáng sợ gọi là Yedoma, một loại băng vĩnh cửu, ảnh hưởng đến sự nóng lên của hành tinh chúng ta.
Sau một đêm thức dậy cơ thể cần được bổ sung nước nhưng nếu uống những loại nước này thì chẳng những khiến bạn chóng già mà còn ảnh hưởng nghiêm trọng tới sức khỏe.
Thịt là nguồn thực phẩm cung cấp nhiều chất dinh dưỡng cần thiết cho cơ thể. Tuy nhiên, khi tiêu thụ quá nhiều thịt, bạn sẽ phải đối mặt với rất nhiều vấn đề sức khỏe. Dưới đây là những dấu hiệu cho thấy bạn đang ăn thịt quá nhiều.
Cực quang hay còn gọi là ánh sáng phương Bắc, từ lâu được xem là bữa tiệc ánh sáng vĩ đại nhất Trái đất với những dải sóng đầy màu sắc.
Bất cứ khi nào các chủ xe tương lai có nhu cầu mua một chiếc xe ô tô cũ hoặc mới thì việc kiểm tra độ an toàn là rất quan trọng.
Đậu phụ là thực phẩm phổ biến tốt cho sức khỏe nhưng không phải ai cũng có thể ăn được.
3 sai lầm khi ăn đậu phụ dưới đây khiến phản tác dụng, dễ rước bệnh vào thân.
3 sai lầm khi ăn đậu phụ dưới đây khiến phản tác dụng, dễ rước bệnh vào thân.
DNVN - Honda Rebel 500 đời 2021 tại Việt Nam vẫn giữ nguyên giá bán 180 triệu đồng như đời cũ. Mẫu cruiser này không có nhiều thay đổi đáng chú ý.
Đậu phụ là thực phẩm phổ biến tốt cho sức khỏe nhưng không phải ai cũng có thể ăn được.
End of content
Không có tin nào tiếp theo